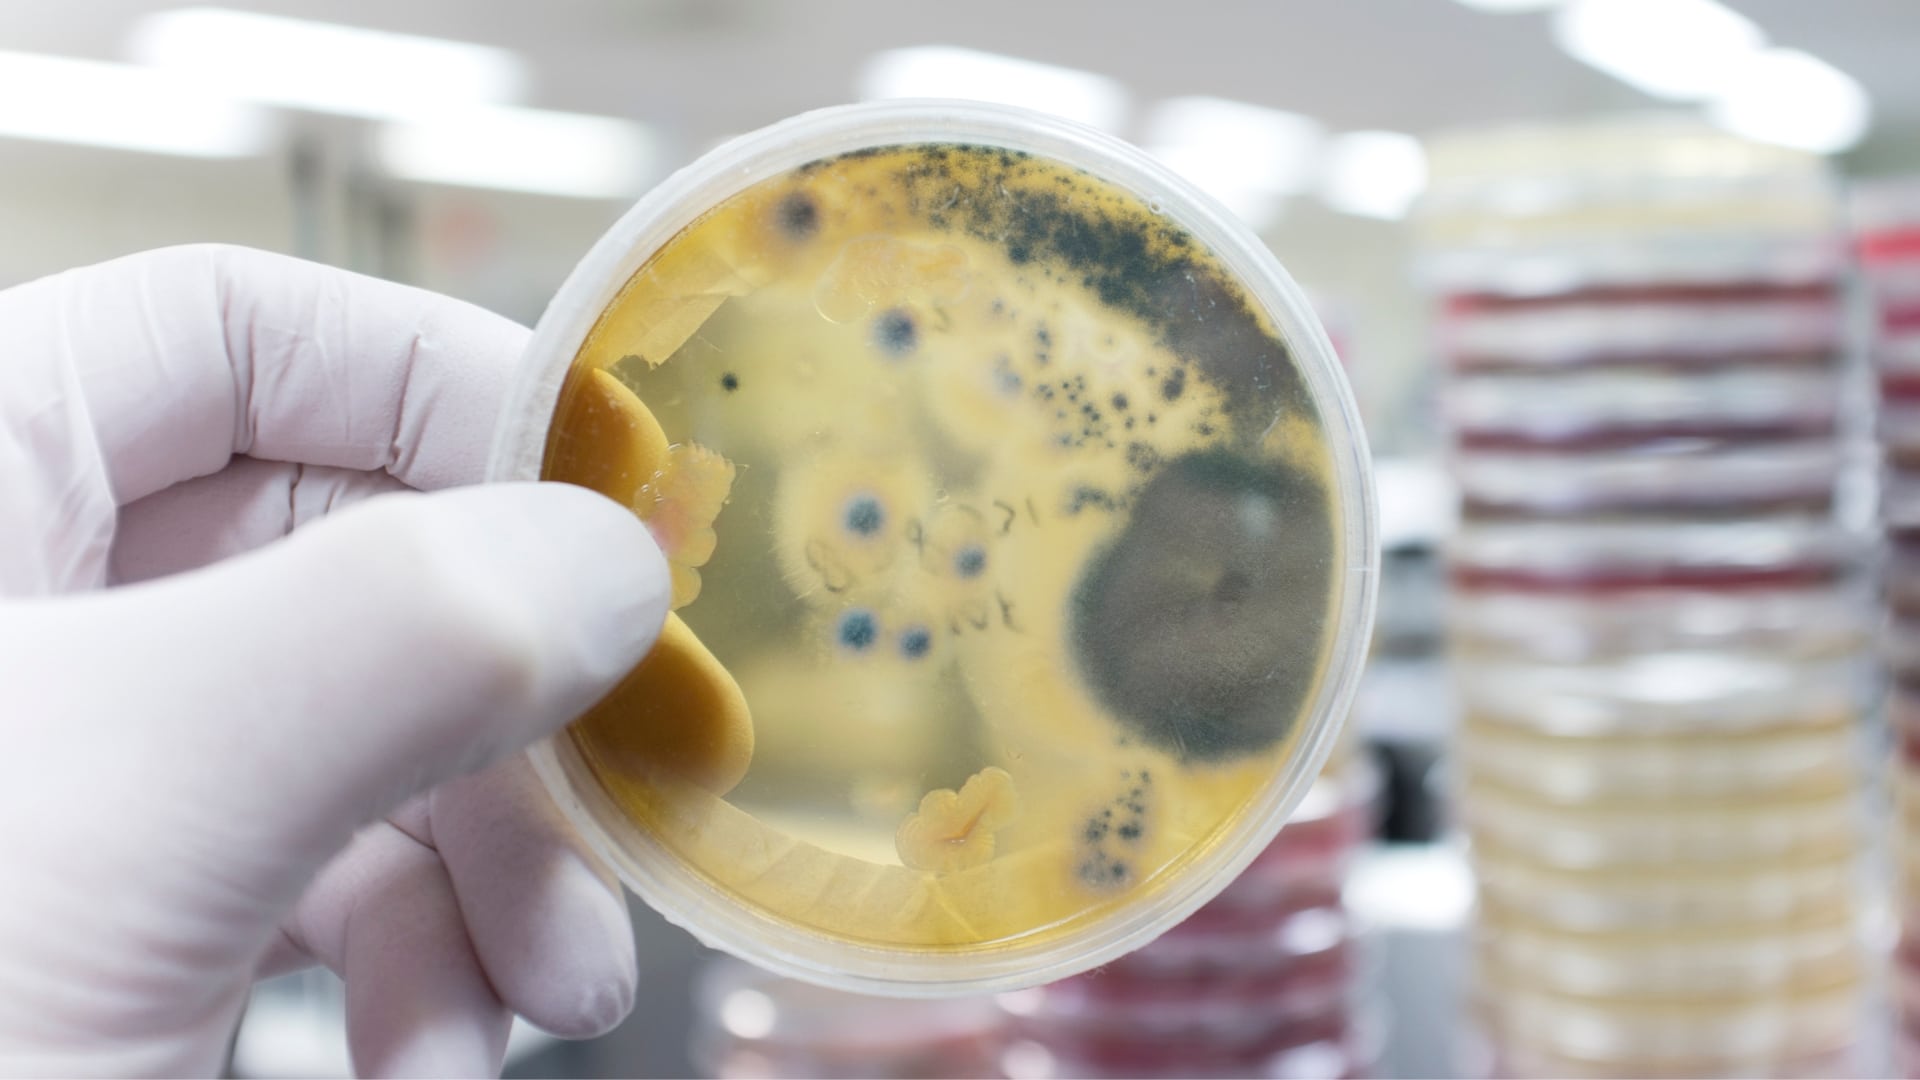

O fungo recebeu o nome Pseudomonodictys pantanalensis, em homenagem ao bioma Pantanal
Um grupo de pesquisadores de Mato Grosso descobriu e identificou uma nova espécie de fungo endofítico no bioma do Pantanal mato-grossense capaz de ajudar a descontaminar solos com ocorrência de mercúrio. A descoberta foi confirmada após os pesquisadores realizarem o sequenciamento do microrganismo.
O fungo recebeu o nome Pseudomonodictys pantanalensis, em homenagem ao bioma Pantanal. Conforme os pesquisadores, ele vive em associação com a planta pantaneira conhecida como Corticeira, ou pelo nome científico Aeschynomene fluminensis, encontrada na região de Poconé (a 105 km de Cuiabá).
De acordo com o coordenador da pesquisa, professor doutor Marcos Antônio Soares, a proposta do trabalho sempre foi encontrar uma solução para remediar a contaminação do solo pelo mercúrio na região próxima de Poconé, por ser um município na região pantaneira que teve um longo período de exploração de ouro, desde a sua descoberta em 1977. O mercúrio é um metal pesado tóxico e pode atacar o sistema nervoso central e periférico, bem como o trato digestivo, sistema imunológico, pulmões e rins.
“A importância do trabalho foi demonstrar que o Pantanal é uma fonte de novas espécies ainda não conhecidas pelo homem, e que podem auxiliar a sociedade a resolver problemas ambientais, como a descontaminação de solos contaminados por metais tóxicos. Esse bioma apresenta uma grande biodiversidade ainda desconhecida, que são verdadeiras ferramentas para uso na descontaminação do solo e outras funções, além de ser um repositório para novas espécies”, afirmou.
Os fungos são organismos vivos muito pequenos e que podem ser vistos com ajuda de uma lupa ou microscópio. Eles vivem no solo, na água ou estão associados a plantas e animais, inclusive ao homem.
LEIA TAMBÉM: UFMG TERÁ LABORATÓRIO ÚNICO NO BRASIL PARA PRODUÇÃO DE TERAPIAS PARA DOENÇAS RARAS
Várias espécies têm importância industrial, na alimentação, produção agrícola, produção de medicamentos, e algumas podem ser utilizadas para descontaminar ambientes. Os fundos são importante para o planeta Terra porque são excelentes na ciclagem e decomposição de nutrientes. Poucas são as espécies que podem causar doenças em plantas, animais e em pessoas.
Pesquisa
O fungo isolado foi descrito pela doutoranda Jaqueline Alves Senabio, do Programa de Doutoramento em Biotecnologia e Biodiversidade do Centro-Oeste (UFMT), e desenvolvido no Laboratório de Biotecnologia e Ecologia Microbiana da Universidade Federal de Mato Grosso (UFMT), sob a orientação do prof. Dr. Marcos Antônio Soares.
A pesquisa foi financiada com o apoio do Governo de Mato Grosso, através da Fundação de Amparo à Pesquisa do Estado de Mato Grosso (Fapemat). O projeto começou em 2014 no Programa de Núcleos de Pesquisa e Emergentes (Pronem), uma parceria com o Conselho Nacional do Desenvolvimento Científico e Tecnológico (CNPq) e Fapemat.
Fonte: Labnetwook
ÚLTIMAS NOTÍCIAS: RESERVATÓRIO EQUIVALENTE DA BACIA DO RIO PARAÍBA DO SUL ATINGE MAIOR ARMAZENAMENTO DOS ÚLTIMOS DEZ ANOS
ÚLTIMAS NOTÍCIAS: PORTO DE SUAPE ANUNCIA PARCERIA COM O REINO UNIDO PARA PROJETO DE INCENTIVO AO HIDROGÊNIO VERDE